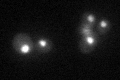
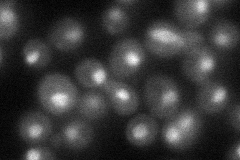

View description
Protein that associates with the INO80 chromatin remodeling complex under low-salt conditions
Localization:
Intensity:
Fold change:
Significance:
-
C’ GFP library in SD
nucleus39.45 -
N' NOP1pr-GFP in SD

cytosol,nucleus83.611 -
N' TEF2pr-mCherry in SD

nucleus75.0194 -
N' NATIVEpr-GFP in SD
nucleus37.0551 -
N' TEF2pr-VC and Cyto-VN in SD

nucleus40.1465 -
C’ GFP library in SD+DTT

nucleus33.440.84No -
C’ GFP library in SD+H2O2

nucleus28.270.71No -
C’ GFP library in Starvation Media

nucleus35.060.88No -
C’ GFP library on the background of Pup2-DaMP

nucleus -
C’ GFP library on the background of CCT mutant

nucleus30.42530.771014No
